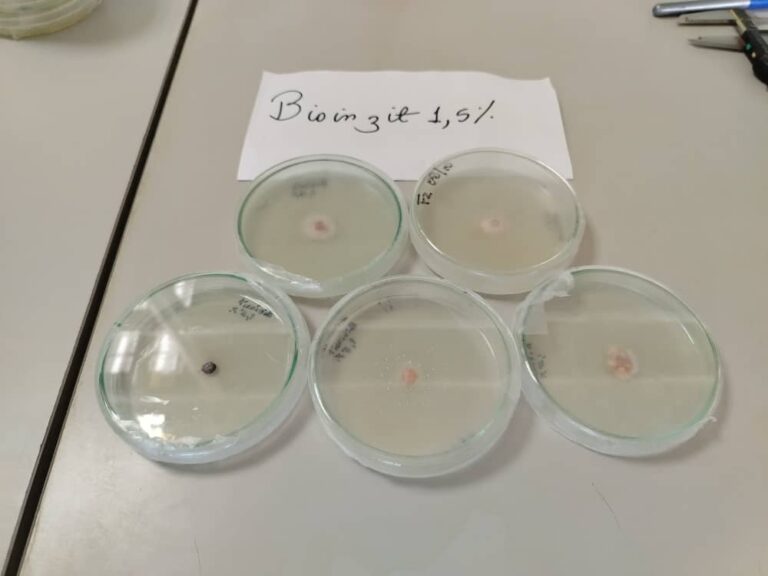
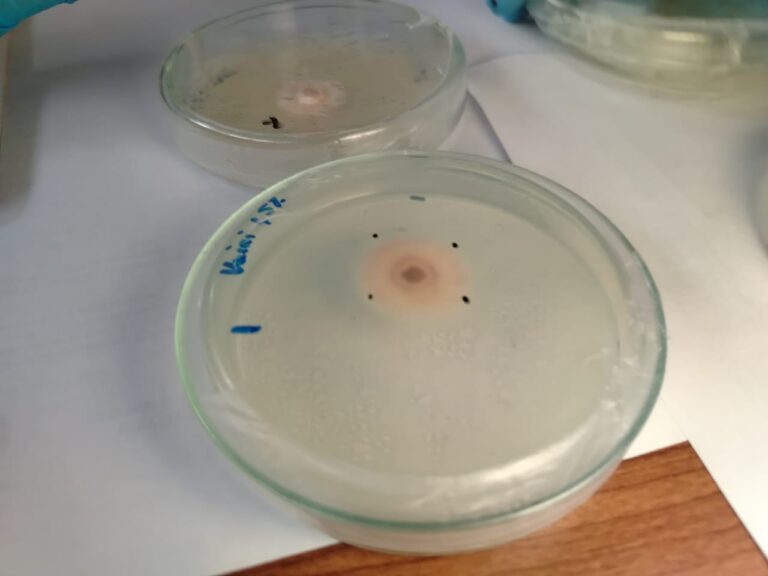

(Caracas, 23 de octubre de 2025).- La Fundación Instituto Zuliano de Investigaciones Tecnológicas (Inzit) a través de su Coordinación de Aprovechamiento de Residuos y Subproductos Industriales, está desarrollando una investigación sobre el efecto antifúngico in vitro del quitosano modificado tipo bases de Schiff en el hongo patógeno Fusarium sp.
El proyecto, liderado por la investigadora Ingrid Antúnez, evalúa el comportamiento de estos compuestos en distintas concentraciones para determinar su capacidad fungistática.
Esta línea de investigación tiene como objetivo ofrecer soluciones sostenibles y de bajo impacto ambiental para el control de patógenos agrícolas, aprovechando residuos industriales como materia prima para el desarrollo de bioinsumos.
“La relevancia de este estudio radica en su potencial para ofrecer soluciones ecológicas al sector agroproductivo, además de abrir nuevas rutas para el aprovechamiento de residuos industriales en aplicaciones científicas”, destacó Antúnez.
Con esta iniciativa, la Fundación Inzit reafirma su compromiso con la innovación científica y la economía circular, impulsando alternativas ecológicas para enfrentar los desafíos del sector agroproductivo, en cumplimiento con la Gran Misión Ciencia, Tecnología e Innovación Dr. Humberto Fernández Morán.
Mincyt / Prensa / Con información del Inzit